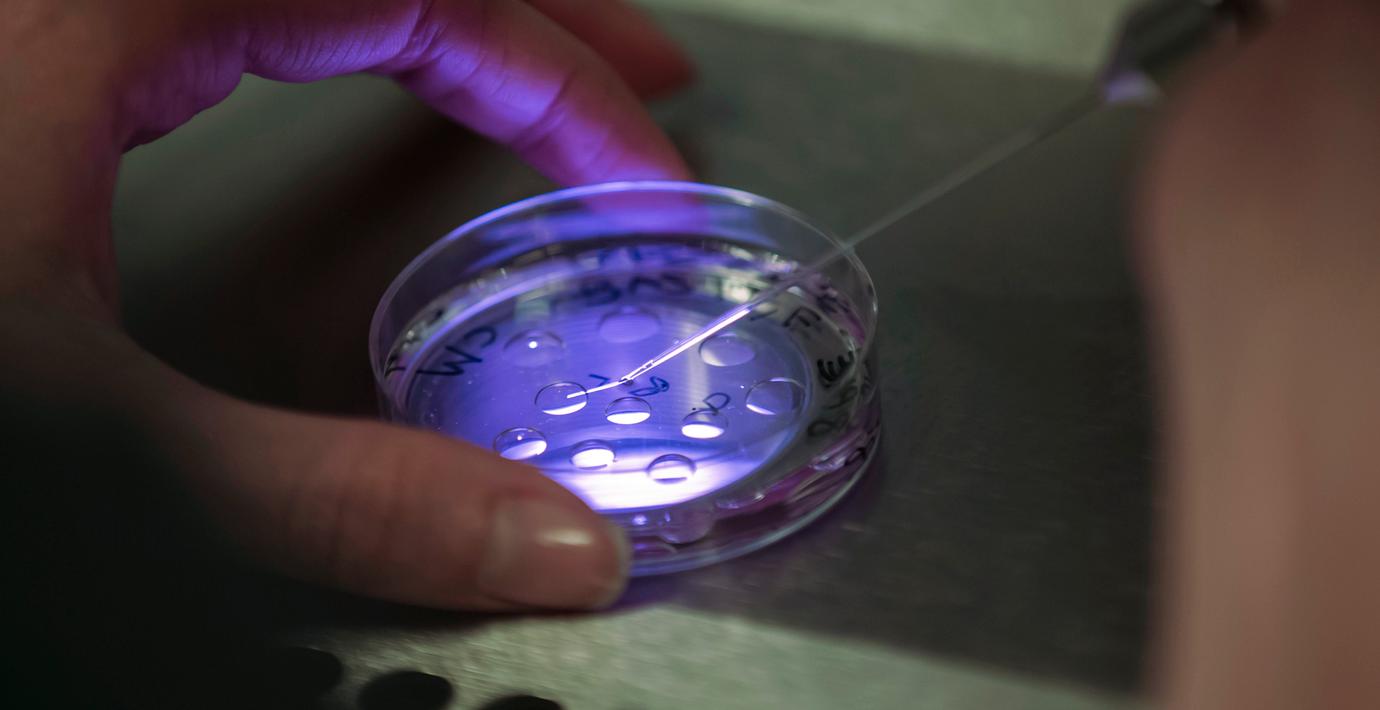

Hyllad fertilitetsläkare använde sin egen sperma
Han var hyllad och gick under namnet bebisguden, men nu har det uppdagats att den kanadensiska fertilitetsläkaren Norman Barwin har använt sin egen sperma för att befrukta kvinnliga patienter, skriver CBS.
1989 vände sig ett par till Bardwin för att få hjälp med assisterad befruktning. Men 25 år senare visade det sig att Bardwin använde sin egen sperma istället för den manlige partnerns.
I ytterligare minst 80 fall ska par som vänt sig till Barwin fått sperma från anonyma givare i stället för från den manlige partnern.
Efter fleråriga förhandlingar har nu en förlikning nåtts där den vanhedrade fertilitetsgurun erbjuder sig att betala sammanlagt motsvarande 92 miljoner kronor, till sammanlagt 226 tidigare patienter och deras barn.
bakgrund
Barwin vann flera fina priser för sina insatser
Wikipedia (en)
Bernard Norman Barwin is a Canadian gynaecologist and former general practitioner and medical professor. He was appointed to the Order of Canada in 1997, but resigned the award in 2013 after admitting to professional misconduct.
Omni är politiskt obundna och oberoende. Vi strävar efter att ge fler perspektiv på nyheterna. Har du frågor eller synpunkter kring vår rapportering? Kontakta redaktionen